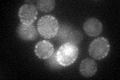
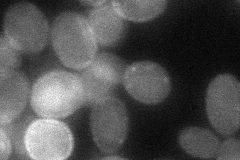

View description
Plasma membrane protein involved in G-protein mediated pheromone signaling pathway; overproduction suppresses bem1 mutations
Localization:
Intensity:
Fold change:
Significance:
-
C’ GFP library in SD
punctate46.27 -
N' NOP1pr-GFP in SD

cell periphery,punctate136.949 -
N' TEF2pr-mCherry in SD

cell periphery166.675 -
N' NATIVEpr-GFP in SD

punctate37.2292 -
N' TEF2pr-VC and Cyto-VN in SD
cell periphery53.2315 -
C’ GFP library in SD+DTT

punctate54.91.18No -
C’ GFP library in SD+H2O2

punctate46.641No -
C’ GFP library in Starvation Media

punctate98.812.13Yes -
C’ GFP library on the background of Pup2-DaMP

punctate -
C’ GFP library on the background of CCT mutant

punctate40.99010.885763No
